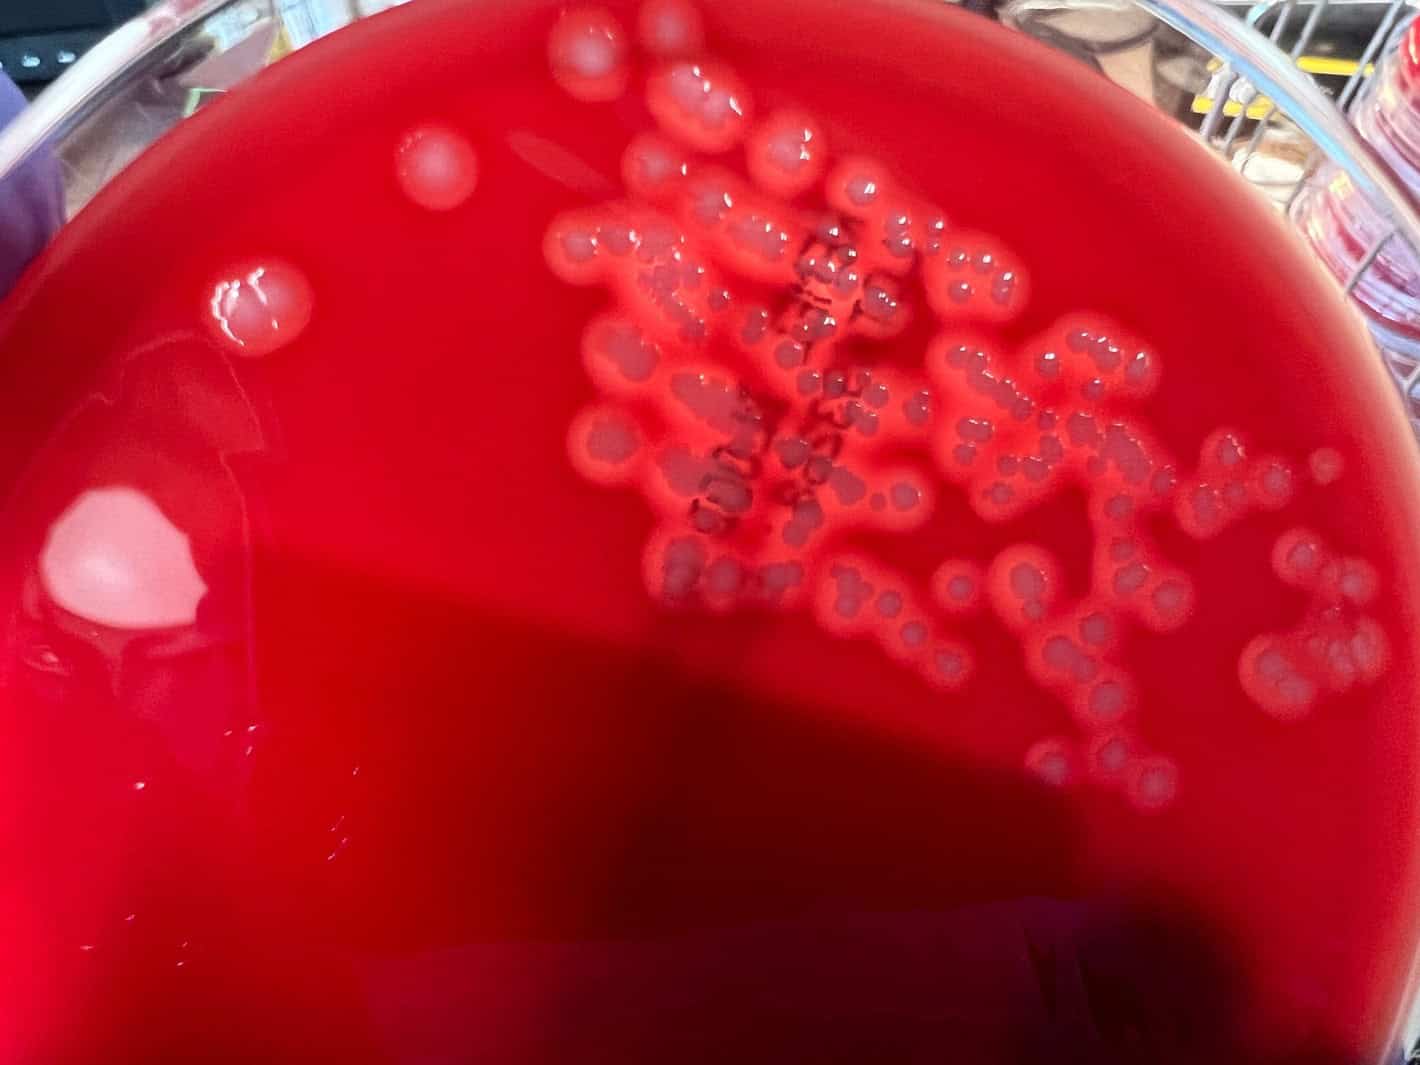

From manual to molecular

Covid-19 set the precedent for the ‘molecularisation’ of healthcare, argues Fiona Smith.
Five years after the Covid-19 outbreak in the UK, the lasting legacy on the diagnostics field is undeniable. During the pandemic, we saw an unprecedented boom in molecular testing as laboratories had to overcome both scientific and operational challenges to meet overwhelming demand.
As they accelerated scientific advances, laboratory teams witnessed first hand the impact of high-throughput molecular testing. Now, in the post-pandemic landscape, many have the infrastructure in place to roll this out on a larger scale in place of tr aditional culture-based methods.
Potential of molecular testing to transform women’s health – a case study
The move from culture-based testing to molecular is already being explored to diagnose Bacterial Vaginitis (BV) and Group B Streptococcus (GBS).
Vaginitis, which encompasses a range of conditions, accounts for approximately 50% of gynaecological presentations, with the main cause including BV [1]. Leaving BV untreated leads to an increased risk of STIs, as well as pregnancy complications, demonstrating a critical need to provide the right result at the right time [2]. However, these conditions can be difficult to diagnose as the bacteria associated with vaginitis are also present in other diseases of the lower vaginal tract.

GBS is another common bacteria that is normally symptomless and harmless, except in the very young and very old – it can cause sepsis, pneumonia and meningitis in newborns [3].
GBS has recently been included in the new UK disease-threat watch list, identified as one of the diseases that could pose the greatest threat to public health, making early and accurate diagnosis crucial [4].
The current gold standard of GBS screening is the use of enriched culture medium with selective agar [5]. However, receiving results is time-consuming, with the incubator and analysis time currently taking between 24-48 hours. This does not account for the time required for sample transportation, analysis and patient follow-up.
In contrast, real-time Polymerase Chain Reaction (PCR) tests can deliver highly specific results in a matter of hours, reducing the number of false results and decreasing turnaround times [6].
Providing early and accurate diagnosis also has an impact on treatment. GBS infection is treated with intrapartum antibiotic prophylaxis (IAP), with targeted PCR screening shown to reduce inappropriate IAP use by 70.5% [7]. Whereas, vaginitis is treatable via a variety of methods dependent on the cause, making accurate diagnosis essential and to reduce the unnecessary use of antibiotics and antifungals.
Overcoming barriers for greater adoption of molecular testing
While there is a critical need for the specificity of molecular testing to reduce overtreatment, cost remains a significant barrier to the wider adoption of molecular testing.
For example, GBS infection testing via PCR is more expensive per test compared to culture testing. However, it is important to consider the wider costs that can result in long-term savings.
Laboratories face challenges and cost pressures every day coupled with a shortage of specialist staff and also a requirement for a greater number of tests per Full-Time Equivalent, while maintaining the turnaround time of results.
Automating high-volume tests onto random access molecular platforms with consolidated menus that combine sexually transmitted diseases, women’s health and viral load testing, provides laboratories with flexibility and reliability. In turn minimising demands on staff, by reducing hands-on time and improving workflow.
Laboratories must also consider the price per square metre, with culture testing requiring significant floor space. At a time when the NHS is under increasing pressure, ensuring laboratories have enough space is vital to save space and cost, and allow the flexibility to scale up capacity and adopt new technologies.
Adopting molecular testing will also require collaboration between different departments. As is the case with BV, traditionally this testing is managed by the bacteriology team, whereas molecular testing sits with virology.
This collaboration could support teams to better share expertise and resources, as well as avoid working in siloes.
What the future holds
As we look ahead to the next five years, and with a need for the NHS to prioritise efficiency and a move from analogue to digital, molecular testing will be one of the k ey ways to achieve this and better support the workforce.
Laboratories must also be prepared for future crises. For example, the World Health Organisation has identified antimicrobial resistance as one of the top global public health and development threats [8]. Diagnosis based on signs and symptoms of disease alone cannot reliably differentiate between bacterial agents, nor discriminate between bacteria, viruses and fungi. Traditional culture-based methods require skilled technicians and time. Automated molecular platforms provide fast turnaround times and automated workflow which can provide timely and appropriate patient management decisions. This also ensures laboratories have the capabilities in place to also respond to future pandemics at speed and at scale.
Now is the time to build on this momentum, and take lessons learned from the pandemic to unlock the full power of molecular testing.

References:
1 Paladine HL, Desai UA. Vaginitis: Diagnosis and Treatment. Am Fam Physician. 2018; 97, 321–329
2 Jain JP, Bristow CC, Pines HA, Harvey-Vera A, Rangel G, Staines H, Patterson TL et al. Factors in the HIV risk environment associated with bacterial vaginosis among HIV negative female sex workers who inject drugs in the Mexico-United States border region. BMC Public Health. 2018; 1032
3 Heath PT, Jardine LA. Neonatal infections: group B streptococcus. BMJ Clin Evid. 2014; 0323
4 BBC News [Internet] UK draws up new disease-threat watch list.[cited 2025 March 26] Available from: https://www.bbc.co.uk/news/articles/cr72d7p5dl2o
5 Hughes, RG, Brocklehurst P, Steer PJ et al. Prevention of Early-onset Neonatal Group B Streptococcal Disease. BJOG. 2017
6 Panther Fusion GBS assay. Instructions for Use. AW-23714- 001 Rev 001. Hologic, Inc.; 2022
7 Hartvigsen CM, Nielsen SY, Møller JK, Khalil MR. Reduction of intrapartum antibiotic prophylaxis by combining risk factor assessment with a rapid bedside intrapartum polymerase chain reaction testing for group B streptococci. European Journal of Obstetrics & Gynecology and Reproductive Biology. 2022; 1;272:173-6
8 World Health Organization [Internet] Antimicrobial resistance. [cited 2025 April 1] Available from: https://www.who.int/news-room/fact-sheets/detail/antimicrobialresistance




